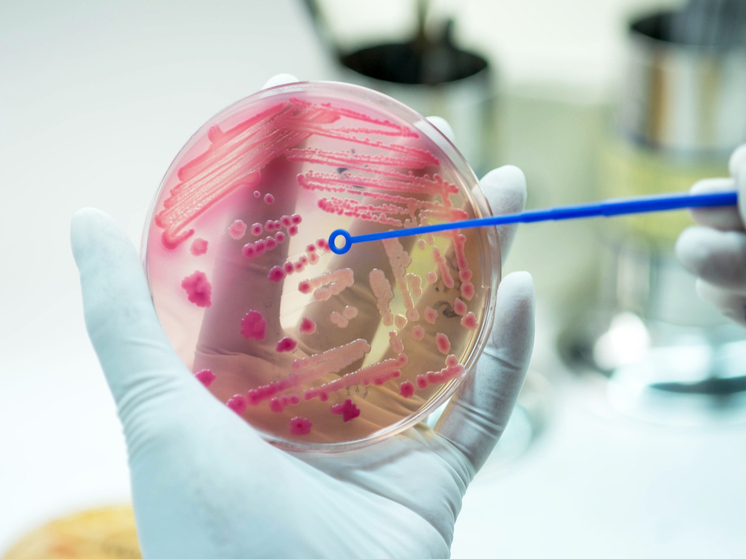

Старшее поколение
Новости
-
15:49
Азотные удобрения ускоряют гибель рыбы и «цветение» озер
-
15:45
В США обвинили Леонеля Месси в мошенничестве
-
15:44
Арестован бывший начальник департамента здравоохранения российского региона
-
15:42
Трамп заявил об открытии Ормузского пролива "для всех"
-
15:36
Два жителя Ярославской области получили сроки за госизмену
-
11:00
От сварки до фасовки: где трудятся российские промышленные роботы
...
Сегодня
...
...
...
...
...
Ощущается как ...
Самое интересное
-
Названа дьявольская хитрость американской морской блокады Ирана

-
Мадьяр призвал президента Венгрии уйти в отставку

-
Чухонский страх: заметив русский военный корабль, эстонцы передумали захватывать танкер «теневого флота»

-
Архитектура мечты: как студенты превращают российские города в пространства жизни

-
Жена подбившего 15 танков ВСУ Героя России высказалась по поводу требований о выкупе